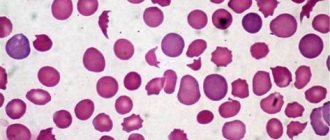

Показания для сдачи анализа
Кровь является одним из самых информативных ресурсов человеческого организма. Отправив ее на лабораторное исследование можно с высокой точностью диагностировать подавляющее большинство заболеваний. Клинический анализ содержит множество показателей, каждый из которых отражает определенный процесс и функцию, служит важным диагностическим критерием. Однако несмотря на изобилие обследований, самым распространённым и востребованным в клинике МедАрт служит общий анализ крови СОЭ.
Скорость оседания эритроцитов — это важнейший показатель, нередко подтверждающий присутствие воспаления или прочей патологии (в острой и скрытой стадии). Механизм этого анализа достаточно прост, поэтому для получения результата не нужно тратить несколько дней. Эритроциты намного тяжелее плазмы и прочих клеточных элементов, в связи с чем, разместив кровь в вертикально размещённой пробирке, спустя определенный промежуток времени на дне ёмкости образуется специфичный осадок, а вверху появится полупрозрачная жидкость.
Это полностью природное явление, которое возникает в результате воздействия силы тяжести. Эритроциты могут слипаться между собой, формируя целые колонии, оседающие на дне сильно быстрее отдельных элементов. Это объясняется большей массой, что может говорить о наличии проблемы.
СОЭ и онкология
При отсутствии воспалительного и инфекционного заболевания значительное повышение СОЭ должно вызывать настороженность в отношении наличия злокачественной опухоли. При первом же подозрении на ее наличие необходима консультация онколога и тщательное дообследование с использованием высокотехнологичной аппаратуры и грамотных специалистов.
Онкология – многофакторное заболевание, сопровождающееся как воспалительными процессами, так и анемией, нарушением обменных процессов, а следовательно — вызывающее выделение организмом большого количества активных веществ, белков. Поэтому большинство больных с различными формами злокачественных опухолей имеют повышенную СОЭ.
Например СОЭ при раке легкого может повышаться при наличии пневмонии около опухоли. При раке толстой кишки или желудка возникает выраженная анемия, что приводит к повышению СОЭ.
Конкретного уровня для каждой опухоли не существует, чаще всего повышение обусловлено сочетанием множества факторов.
Самый высокий уровень СОЭ (80-90мм/ч и более), связанный с онкологией, обычно определяется при заболеваниях, объединенных в группу «парапротеинемий» (Миеломная болезнь, макроглобулинемия Вальденстрема). При этих заболеваниях в крови появляются структурно аномальные и функционально неполноценные белки, что и приводит к изменениям в крови.
Как подготовиться к сдаче анализа
СОЭ входит в список стандартных показателей, которые отображаются во всех исследованиях крови (общих и клинических). Однако особое внимание ему уделяется в следующих ситуациях:
- Подтверждение диагноза
- Профилактическое обследование
- Оценка эффективности назначенного лечения
- Инфекционные и воспалительные патологии
- Аутоиммунные расстройства
- Опухоли (злокачественные и доброкачественные) любой локализации
Многие патологии внутренних органов просекают бессимптомно и нередко выявление отклонения СОЭ от нормы становится поводом начать более детальную диагностику, благодаря чему удаётся определить проблему на ранних этапах и начать эффективное лечение. Чаще всего, после нахождения каких-либо отклонений назначается дополнительный биохимический анализ, позволяющий более детально изучить кровяное русло.
Что делать при повышенном СОЭ
Если человек во время планового медосмотра сдавал анализ крови и в нём нашли повышенное СОЭ, а других отклонений от нормы нет, скорее всего, это не страшно. Чтобы избавиться от сомнений, врач должен назначить The erythrocyte sedimentation rate. Still a helpful test when used judiciously повторный тест через несколько месяцев.
Но тем, у кого есть другие изменения в крови, может понадобиться дополнительное обследование. Какое — будет решать специалист, который заметил повышенное СОЭ.
Как проводится исследование
Точность этого диагностического метода зависит от многих нюансов: правильная подготовка к сдаче, профессионализм работника лаборатории и качество реагентов. При соблюдении этих условий можно гарантировать получение максимально достоверного результата. И если на последние 2 пункта человек, сдающий кровь, повлиять не может, то подготовительный этап полностью зависит от него. Несмотря на то, что в этом случае не требуется специальная и сложная подготовка, есть ряд обязательных общих правил, которых настоятельно рекомендуется придерживаться.
В первую очередь, за 1 день до сдачи необходимо отказаться от распития алкогольных напитков, а также воздержаться от приема пищи за 4-5 часов. Допускается только питье обычной воды. Также, за час до анализа рекомендуется отказаться от курения. Во-вторых, если пациент принимает (на постоянной основе или только в данный момент) какие-либо лекарственные препараты, то об этом необходимо заблаговременно сообщить врачу. Некоторые медикаменты могут искажать результаты, из-за чего их приём может быть приостановлен и восстановлен после сдачи крови. В третьих, накануне процедуры не стоит посещать спортивные или тренажёрные залы. Также стоит воздержаться от сильных физических нагрузок и избегать эмоциональных стрессов.
Если же вы сомневаетесь в чем-то, то просто позвоните нам по данному номеру +375(29) 666-30-96 либо запишитесь на консультацию к врачу с помощью нашей онлайн формы.
Как подготовиться
Длительность анализа не превышает 5-10 минут. Как правило, процедура сопровождается незначительной болезненностью и дискомфортом в области прокола, но неприятные ощущения проходят очень быстро. Если необходима капиллярная кровь, то прежде, чем проколоть третий или четвёртый палец левой руки, кожа в этом месте обрабатывается спиртовым ватным шариком. После этого, при помощи специального медицинского лезвия, осуществляется небольшой надрез на подушечке пальца (его глубина не превышает 3 миллиметров). Полученная капля крови утилизируемая стерильной салфеткой, посла чего лаборант проступаете к сбору биоматериала. Собрав нужное количество, раневая поверхность смазывается антисептиком, а на место проколах прикладывается ватка со спиртом.
Если анализ предусматривает взятие биоматериала из вены, то предплечье пациента стягивается медицинским жгутом или ремешком, после чего он должен немного поработать кулаком (сжать и разжать) для лучшего сосудистого наполнения. Место предполагаемого прокола обрабатывается спиртовой салфеткой, после чего в выбранный сосуд вводится игла, к которой подсоединяется пробирка для накопления выпущенной крови. Набрав достаточное количество биоматериала, игла извлекается, а к ране прикладывается ватка со спиртом.
Для подсчета СОЭ в биологический материал помещается антикоагулянт, не допускающий свертывание. Затем она отправляется в вертикально расположенную ёмкость на 60 минут. Так как удельный вес эритроцитов превышает вес плазмы, сила тяжести спускают их на дно ёмкости. Из-за этого в пробирке образуется 2 видимых слоя: верхний (бесцветная плазма) и нижний (эритроцитарные скопления). Затем лаборант осуществляет замер верхнего слоя. Показатель, соответствующий отметке между эритроцитами и плазменной зоной на пробирочной шкале — это СОЭ (указывается в мм/ч).
Сегодня применяется 2 основных способа выявления СОЭ:
- Метод Панченкова. Капилляр разделяется ровно на сто отделений, позже в него добавляется 5% цитрат натрия до уровня «Р». Затем капилляр наполняется биоматериалом до буквы «К». Полученная смесь смешивается и устанавливается вертикально. Оценивание проводится спустя 60 минут.
- Метод Вестергрена. Здесь используется венозная кровь, перемешиваемая с цитратом натрия 3,8% в отношении 4:1. Допускается её смешение с трилот Б с последующим добавлением цитрата натрия или физ раствора в количестве 4:1. Исследование осуществляется в пробирках, оснащённых шкалой в 200 мм. Результат оценивается через 60 минут. Эта методика используется повсеместно, а ее принципиальной отличительной чертой является тип применяемых пробирок и мерной шкалы.
Несмотря на совпадение результатов этих способов, метод Вестергрена славится большей чувствительностью к превышению показателя СОЭ, в связи с чем он считается высокоточным и информативным.
Показатели нормы MCH
Цифра варьируется у разного от пола и возраста. Для новорожденных (до 1 месяца) СОЭ составляет от 1 до 2 мм/ч. Эти границы объясняются пониженной белковой концентрацией. От 1 месяца до полугода он составляет от 12 до 17 мм/ч. Это резкое увеличение нормы объясняется возрастными процессами, возникающими в подрастающем организме. Затем данные стабилизируются — для ребенка до 10 лет нормальными границами считаются цифры от 1 до 10 мм/ч.
Так как вязкость крови имеет несколько половых отличий, то норма СОЭ будет различной для мужчин и женщин. У представительниц прекрасного пола от 10 до 50 лет допустимыми границами являются 0-20 мм/ч, а от 50 лет — от 0 до 30 мм/ч. Цифра может изменяться во время беременности, что служит нормальным явлением, но требует контроля лечащего врача. У мужчин от 10 до 50 лет этот показатель должен составлять от 0 до 15 мм/ч, а старше 50 лет — от 0 до 20 мм/ч.
| Возраст, лет | Норма СОЭ |
| Ребенок до 1 месяца | 1-2 мм/ч |
| Ребенок 1 месяц — 6 месяцев | 12-17 мм/ч |
| Ребенок до 10 лет | 1-10 мм/ч |
| Женщина 10-50 | 0-20 мм/ч |
| Женщина старше 50 | 0-30 мм/ч |
| Мужчина 10-50 | 0-15 мм/ч |
| Мужчина старше 50 | 0-20 мм/ч |
На конечный результат оказывает влияние множество факторов: неправильная подготовка, волнение, приём лекарственных препаратов и многое другое. Помимо этого, значение может зависть даже от времени дня. Как правило, максимум определяется около полудня.
Что такое СОЭ
Скорость оседания эритроцитов (СОЭ) – показатель, определение которого входит в общий анализ крови. Это неспецифический лабораторный скрининговый тест, изменение которого может служить косвенным признаком текущего воспалительного или иных патологических процессов, таких как злокачественные опухоли и диффузные заболевания соединительной ткани
ФАКТОРЫ, ВЛИЯЮЩИЕ НА ПОКАЗАТЕЛЬ СОЭ
Показатель СОЭ меняется в зависимости от множества физиологических и патологических факторов.
Значения СОЭ у женщин несколько выше, чем у мужчин.
Изменения белкового состава крови при беременности ведут к повышению СОЭ в этот период.
Снижение содержания эритроцитов (анемия) в крови приводит к ускорению СОЭ и, напротив, повышение содержания эритроцитов в крови замедляет скорость седиментации.
В течение дня возможно колебание значений, максимальный уровень отмечается в дневное время.
Основным фактором, влияющим на образование «монетных столбиков» при оседании эритроцитов является белковый состав плазмы крови.
Острофазные белки, адсорбируясь на поверхности эритроцитов, снижают их заряд и отталкивание друг от друга, способствуют образованию монетных столбиков и ускоренному оседанию эритроцитов.
Повышение белков острой фазы, например, С-реактивного белка, гаптоглобина, альфа-1-антитрипсина, при остром воспалении приводит к повышению СОЭ.
При острых воспалительных и инфекционных процессах изменение скорости оседания эритроцитов отмечается через 24 ч после повышения температуры и увеличения числа лейкоцитов.
При хроническом воспалении повышение СОЭ обусловлено увеличением концентрации фибриногена и иммуноглобулинов.
Некоторые морфологические варианты эритроцитов также могут оказывать влияние на СОЭ. Анизоцитоз и сфероцитоз ингибируют агрегацию эритроцитов. Макроциты имеют заряд, соответствующий их массе, и оседают быстрее.
При анемии дрепаноциты оказывают влияние на СОЭ так, что даже при воспалении СОЭ не возрастает.
ПРИЧИНЫ ИЗМЕНЕНИЯ ПОКАЗАТЕЛЕЙ СОЭ
Нормальные значение СОЭ
Зависит от пола и возраста:
- у новорожденных СОЭ очень замедленна — около 2мм, что связано с высокой величиной гематокрита и низким содержанием глобулинов
- к 4 неделям СОЭ слегка ускоряется
- к 2 годам она достигает 4-17 мм
- у взрослых и детей старше 10 лет СОЭ составляет от 2 до 10 мм для мужчин и от 2 до 15 мм для женщин, что может быть объяснено разным уровнем андрогенных стероидов
- у пожилых людей нормальный уровень СОЭ колеблется в пределах от 2 до 38 у мужчин и от 2 до 53 у женщин.
Повышение значения СОЭ
Наиболее частой причиной повышения СОЭ является увеличение содержания в плазме крупнодисперсных белков (фибриногена, a- и g-глобулинов, парапротеинов), а также уменьшение содержания альбуминов. Крупнодисперсные белки обладают меньшим отрицательным зарядом. Адсорбируясь на отрицательно заряженных эритроцитах, они уменьшают их поверхностный заряд и способствуют сближению эритроцитов и более быстрой их агломерации.
- Инфекции, воспалительные заболевания, деструкция тканей.
- Другие состояния, приводящие к повышению содержания фибриногена и глобулинов в плазме, такие, как злокачественные опухоли, парапротеинемии (например, макроглобулинемия, множественная миелома).
- Инфаркт миокарда.
- Пневмония.
- Заболевания печени — гепатит, циррозы печени, рак и др., ведущие к выраженной диспротеинемии, иммунному воспалению и некрозам ткани печени.
- Заболевания почек (особенно сопровождающиеся нефротическим синдромом (гипоальбуминемия) и другие).
- Коллагенозы.
- Заболевания эндокринной системы (диабет).
- Анемии (СОЭ увеличивается в зависимости от тяжести), различные травмы.
- Беременность.
- Отравления химическими агентами.
- Пожилой возраст.
- Интоксикации.
- Травмы, переломы костей.
- Состояние после шока, операционных вмешательств.
Наиболее значительное повышение СОЭ (до 50–80 мм/ч) чаще всего наблюдается при:
- парапротеинемических гемобластозах — миеломная болезнь, болезнь Вальденстрема
- заболеваниях соединительной ткани и системных васкулитах — системная красная волчанка, узелковый периартериит, склеродермия и др.
Понижение значения СОЭ
- сгущение крови
- ацидоз
- Полицитемия.
- Серповидноклеточная анемия.
- Сфероцитоз.
- Гипофибриногенемия.
- Гипербилирубинемия.
- Голодание, снижение мышечной массы.
- Прием кортикостероидов.
- Беременность (особенно 1 и 2 семестр).
- Вегетарианская диета.
- Гипергидратация.
- Миодистрофии.
- Выраженные явления недостаточности кровообращения
Наиболее частой причиной значительного уменьшения СОЭ является увеличение вязкости крови при заболеваниях и синдромах, сопровождающихся увеличением числа эритроцитов (эритремия, вторичные эритроцитозы).
ЗАКЛЮЧЕНИЕ
В заключение необходимо заметить, что, несмотря на широкое применение в клинической практике, определение СОЭ имеет ограниченное диагностическое значение. Вместе с тем, большинство авторитетных экспертов в области клинической медицины, однозначно указываю на то, что диагностические возможности этого метода используются далеко не полностью, и основная проблема для практики отечественных КДЛ лежит в плоскости методических особенностей постановки теста. Представленные два метода, метод Панченкова и метод Вестергрена для определения СОЭ, очень нужные методы, ведь с помощью них можно подтвердить различные воспаления. Но нужно быть внимательным, ведь для исследований нужно соблюдать четкое выполнение правил анализа с использованием современных разработок, не только улучшающих качество результатов теста, но и существенно повышающих безопасность пациента и персонала при взятии проб крови. В ближайшем будущем планируется выпуск многопараметрических смарт-карт, наряду с СОЭ позволяющих оценивать фактор анемии, фактор агрегации, вязкость, индекс гематокрита и индекс гемоглобина.
Выводы:
СОЭ — неспецифический лабораторный показатель крови, изменение СОЭ может служить косвенным признаком текущего воспалительного процесса и является актуальным до настоящего времени;
При исследовании СОЭ различными методами получаются разные результаты;
Показатель СОЭ из венозной крови значительно выше, чем из капиллярной крови;
Метод Панченкова технологически устарел, занимает больше времени, чем другие методы определения СОЭ;
При выполнении СОЭ методом Панченкова сложнее соблюдать санитарно – эпидемиологический режим.
Заведующий клинико-диагностической лабораторией Татьяна Шах
Повышение СОЭ
Подобный результат может обуславливаться следующими патологиями:
- Инфекция или воспаление.
- Заболевания соединительной ткани (РА, СКВ, васкулит и т.д.).
- Ожоговая болезнь.
- Новообразования разной этиологии и локализации.
- Инфаркт миокарда. В постинфарктном периоде максимум наступает спустя примерно 7 дней (в таком случае вам необходимо обратиться к сосудистому хирургу).
- Анемии. Для этих болезней характерно снижение эритроцитов и повышение скорости их оседания.
- Травмирование.
- Амилоидоз (патология, характеризующаяся формированием патологического белка — амилоида).
Несмотря на несоответствие нормальным границам, если общий анализ крови СОЭ показал увеличение этого показателя, это не обязательно указывает на присутствие проблемы. Такой результат возникает и у здоровых лиц: у женщин во время менструального цикла, в период беременности или у лиц с лишним весом. Также это возникает при приёме ряда лекарственных веществ, поэтому нужно заранее проконсультироваться с врачом.
Естественные причины повышения скорости оседания эритроцитов
Если СОЭ повышен, это может быть вызвано разными причинами, однако не всегда это злокачественные опухоли.
- У женщин СОЭ возрастает в период менструации, а также и при беременности. Абсолютной нормой для беременной женщины будет 44-46 мм/час, однако помните, что в начале беременности СОЭ, наоборот, снижен.
- Причиной повышенного оседания может быть стресс, чрезмерное напряжение и эмоциональные нагрузки.
- Также этот показатель возрастает при аллергических реакциях организма.
- Различные реакции, воспаления при порезах или занозах тоже служат причиной.
- Обратите внимание на препараты, которые вы принимаете – иногда СОЭ возрастает из-за них.
Приведенные выше причины не являются самыми серьезными. Если речь идет о естественных процессах в организме женщины – беспокоиться совершенно не нужно. Другое дело, когда СОЭ повышается из-за внутреннего воспаления, которое может перерасти в опасную болезнь.
Поэтому так важно не прибегать к самолечению, и выяснить у врача причину высокого показателя.
Понижение СОЭ
Сниженная скорость оседания эритроцитов нередко сигнализирует о присутствии расстройств водно-солевого обмена или активной мышечной дистрофии. Нередко это симптом эритроцитоза, лейкоцитоза, наследственного сфероцитоза, гепатитов и ДВС-синдрома. Кроме этого, подобный результат характерен для полицитемии и приводящих к ней состояний (ХСН или поражение лёгочной системы). Низкая СОЭ также может быть следствием голодания, вегетарианства, приема ряда стероидных гормонов, а также часто выявляется в 1 и 2 триместре беременности.
Сдать анализ СОЭ а также пройти другие гематологические исследования вы сможете в нашем медицинском центре МедАрт. С помощью современного оборудования вы сможете узнать абсолютно точные показатели, а высококвалифицированные работники грамотно проконсультируют вас по тому или иному вопросу.